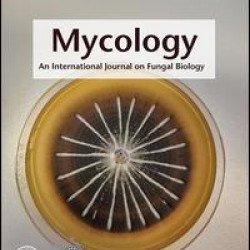

Plant Science
Brand: Taylor & Francis
Model: 2040-6118
Botany Letters is an international scientific journal, published by the French Botanical Society (Société botanique de France) in partnership with Taylor & Francis. Botany Letters replaces Acta Botanica Gallica, which was created in 1993, building on over a century of renowned publications by the So..
₹34,408.80
Brand: Taylor & Francis
Model: 1715-2992
2017 Impact Factor - 0.898Ranking: 157/222 (Plant Sciences) 2017 5 Year Impact Factor - 1.154© 2017 Journal Citation Reports, Clarivate Analytics 2018Canadian Journal of Plant Pathology is an international journal which publishes the results of scientific research and other information relevant to t..
₹30,763.80
Brand: Taylor & Francis
Model: 1469-2961
Published by the Firenze University Press from 2019. 2017 Impact Factor - 0.608 Ranking: 157/171 (Genetics & Heredity)Ranking: 188/222 (Plant Sciences)5 Year Impact Factor - 0.672 ©2017 Journal Citation Reports, Clarivate Analytics 2018® Caryologia: International Journal of Cytology, Cytosystematics..
₹28,795.50
Brand: Taylor & Francis
Model: 2158-0715
Forest Science and Technology is an international journal publishing original research articles and reviews. Papers will deal with all aspects of forest science including: forest biology, silviculture, physiology, and genetics forest operations engineering and management forest assessment modell..
₹0.00
Brand: Taylor & Francis
Model: 1743-7873
Scope: Research papers in all aspects of forest operations, both empirical and theoretical. Most published articles are original research, but review articles are also welcome. An important role of the International Journal of Forest Engineering (IJFE) is to report on existing practices and innovati..
₹28,649.70
Brand: Taylor & Francis
Model: 1469-9672
Webbia is a peer-reviewed journal on Plant Systematics, Nomenclature, Phylogeny, Phytogeography and Paleobotany. Most of the contributions deal with the Vascular Plants, but sometime contributions on Briophytes, Lichenes, Fungi and Algae are encouraged...
₹27,118.80
Brand: Taylor & Francis
Model: 2150-1211
Free online access: Inaugural issue Mycology aims to provide a platform to meet the needs of a demanding and growing field, and to serve and engage dialogue between Chinese mycologists and the international community. Mycology publishes papers in all fields of mycology including fungi, fungus-like o..
₹0.00
Brand: Taylor & Francis
Model: 1755-1668
Plant Ecology and Diversity is an international journal for communicating results and novel ideas in plant science, in print and on-line, six times a year. All areas of plant biology relating to ecology, evolution and diversity are of interest, including those which explicitly deal with today's high..
₹90,833.41
Brand: Taylor & Francis
Model: 1349-1008
Plant Production Science publishes original research reports on field crops and resource plants, their production and related subjects, covering a wide range of sciences; physiology, biotechnology, morphology, ecology, cropping system, production technology and post harvest management. Studies on pl..
₹0.00
Showing 1 to 9 of 9 (1 Pages)